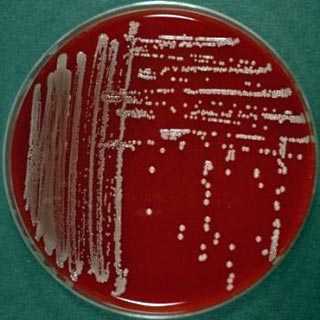

Бактериальная инфекция горла: 4 народных рецепта

Боль в горле — довольно частое явление. Обычно она проходит сама собой через несколько дней. При этом человек испытывает сухость в горле и ему больно глотать — все это говорит о том, что есть бактериальная инфекция.
Как передает Day.Az, об этом пишет steptohealth.ru.
Сегодня мы расскажем вам основные факты об этой небольшой, но неприятной проблеме. Если у вас бактериальная инфекция горла, вам пригодятся рецепты этих 4 народных средств.
Причины появления боли в горле
Инфекция горла может быть вирусного или бактериального происхождения.
Существует 2 основные причины, по которым может болеть горло: это воздействие вирусов или бактерий.
- Вирусная инфекция: встречается гораздо чаще, так как вирус гриппа или простуды легко передается воздушно-капельным путем.
- Бактериальная инфекция: ее можно определить по боли и воспалению. Именно эти симптомы являются наиболее характерными. В этой группе заболеваний можно выделить стрептококковый фарингит. Как ясно из названия, его вызывает бактерия стрептококк.
Бактериальная инфекция горла: основные симптомы
Итак, если у вас бактериальная инфекция, скорее всего вы почувствуете следующие симптомы.
- Высокая температура
- Воспаление миндалин
- Головная боль
Если же, напротив, воспаление вызвано вирусом, картина будет немного иной:
- Кашель
- Заложенный нос
- Боль в горле
Бактериальная инфекция: как с ней справиться?
Много пейте, отдыхайте и избегайте вредных привычек — все это поможет справиться с дискомфортом в горле.
Для того чтобы ваше самочувствие улучшилось, стоит последовать этим рекомендациям:
Пейте больше воды
Постоянно пейте воду, причем она должна быть комнатной температуры. Так вы избежите сухости в горле, и боль будет не такой сильной.
Дело в том, что обезвоживание значительно ухудшает состояние при фарингите. Именно поэтому вы чувствуете более сильную боль по утрам, ведь горло пересыхает за ночь. Для того чтобы поддерживать водный баланс, вы можете сосать леденцы от боли в горле. Помимо оказания местного обезболивающего эффекта, они стимулируют выработку слюны, что необходимо для вымывания бактерий из дыхательных путей.
Откажитесь от курения
От этой привычки в принципе полезно будет избавиться. Но если вы все же курите, постарайтесь не делать этого хотя бы пока у вас болит горло. Ведь это намного задержит выздоровление.
Табачный дым провоцирует дискомфорт и усиливает боль. Это уже не говоря о том, что он может вызвать такие серьезные проблемы, как рак горла.
Ужинайте не позже чем за 2 часа перед сном
Это естественным образом предотвратит подъем желудочного сока вверх по пищеводу, что также может усиливать жжение и боль в горле. Если вы поужинаете за два часа до сна, процесс пищеварения успеет закончиться и риск такой проблемы значительно снизится.
Отдыхайте
Отдых всегда полезен, даже в тех случаях, когда вам так не кажется. Если хорошо высыпаться, ваш ум будет гораздо более ясным, а тело — бодрым.
Так что позаботьтесь о том, чтобы спать ночью не меньше 8 часов. Во-первых, это полезно для хорошего здоровья в целом. Во-вторых, бактериальная инфекция пройдет гораздо быстрее.
Бактериальная инфекция горла: средства первой помощи
Не стоит сразу же прибегать к помощи антибиотиков. Дело в том, что они не действуют против вирусов, только против бактерий. Другими словами, если боль в горле имеет вирусное происхождение, антибиотики будут бесполезны.
Если в вашем случае имеет место бактериальная инфекция, врач может назначить лечение антибиотиками. Наиболее распространенным заболеванием горла является острый фарингит. Вот его основные симптомы:
- Высокая температура
- Внезапная боль в горле
- Чихание
- Простуда
- Кашель
В этом случае, как и при большинстве других заболеваний, специалисты не советуют злоупотреблять антибиотиками. В противном случае бактерии получат к ним иммунитет, и лекарства перестанут действовать. Для начала лучше попробовать справиться с болезнью при помощи натуральных средств.
Бактериальная инфекция: 4 эффективных народных средства
Некоторые натуральные средства помогут вам быстро вылечить воспаленное горло
1. Чесночный чай
Если у вас бактериальная инфекция горла, вам поможет чеснок. Этот натуральный антибиотик быстро справится с вредоносными микроорганизмами.
Ингредиенты
- 3-4 зубчика чеснока
- 2 чашки воды (500 мл)
Приготовление
- Раздавите зубчики чеснока. Доведите воду до кипения.
- Когда вода закипит, добавьте чеснок и варите еще 5 минут.
- Снимите с огня и дайте напитку настояться. Затем процедите чесночный чай и пейте.
2. Чай из эхинацеи
Это растение обладает удивительными свойствами. Например, оно стимулирует иммунную систему. Помимо этого, эхинацея полезна для лечения респираторных заболеваний, таких как грипп или простуда.
Чай из эхинацеи активизирует естественные защитные механизмы, особенно когда вы чувствуете упадок сил из-за болезни. Таким образом организм может успешно бороться с вирусами и бактериями. Пейте этот чай натощак перед сном.
Ингредиенты
- 2 чашки воды (500 мл)
- мед (в качестве подсластителя)
- 2 чайные ложки сушеных соцветий эхинацеи (10 г)
Приготовление
- Во-первых, налейте в ковшик воду и засыпьте цветы эхинацеи.
- Затем варите на среднем огне в течение 7 минут.
- Дайте настояться еще 7 минут, а затем процедите и пейте.
3. Имбирный чай
Лечебные свойства этого корня известны с древних времен. Он помогает от многих болезней. В случае инфекции гортани он действует как мощный природный антибиотик, который уничтожает бактерии и вирусы. Для того чтобы воспользоваться всеми его полезными свойствами, советуем использовать свежий корень имбиря, а не порошок.
Ингредиенты
- 1 чашка воды (250 мл)
- столовая ложка тертого корня имбиря (15 г)
- Вскипятите воду и, когда она закипит, добавьте тертый имбирь.
- Варите 5 минут, а затем снимите с огня.
- Дайте настояться и пейте.
4. Чай из лука
Да, это не опечатка, мы действительно предлагаем вам приготовить луковый чай. Дело в том, что лук прекрасно помогает при боли в горле. Ведь помимо витамина С он содержит кверцетин и изотиоцианаты. Эти вещества действуют как антиоксиданты и снимают воспаление, помогая таким образом очистить дыхательные пути.
Ингредиенты
- 2 стакана воды
- 1 луковица
Приготовление
- Хорошо вымойте лук и нарежьте его полукольцами.
- Положите в кастрюлю с водой и доведите до кипения.
- Снимите с огня, дайте настояться 5 минут, а затем пейте.
В большинстве случаев с болью в горле можно справиться при помощи этих натуральных рецептов. Тем не менее если вы видите, что они не очень помогают, лучше будет обратиться к врачу: он поставит точный диагноз и выпишет вам более сильные препараты.
15 000-dək krediti 15 dəqiqəyə əldə et!
news.day.az
Какие бывают инфекции горла | Медик03
Содержание материала
- Виды воспалительных поражений
- Вирусное поражение носоглотки
- Бактериальное воспаление
- Грибковые процессы в глотке
- Медикаментозные препараты и вспомогательные средства
Инфекционные заболевания носоглотки составляют наибольшую группу ежедневных обращений за медицинской помощью как у детей, так и у взрослых. Назначение антибиотиков не всегда оправдано, а лечение инфекции горла должно зависеть от того, какой возбудитель вызвал то или иное заболевание. Разберем самые частые инфекции, их проявление и возможное лечение горла.
ВАЖНО ЗНАТЬ!
Единственное средство от МОКРОТЫ, которое действительно эффективно и помогает практически сразу
>>>
Ежедневно организм человека сталкивается с множеством возбудителей заболеваний. И не каждая иммунная система способна противостоять этой атаке. Инфекции горла среди числа других заболеваний встречаются чаще всего.
Инфекционными возбудителями могут быть бактерии, вирусы и грибки. Попадая на слизистую зева, они размножаются и атакуют клетки организма, провоцируя воспалительный процесс. От типа возбудителя инфекции в горле зависят симптомы заболевания, их тяжесть и лечение.
Виды
Чаще всего горло поражают следующие инфекции.
Вирусная инфекция горла
Из названия очевидно, что факторами заражения являются вирусы — неклеточная микрофлора. Чтобы начать размножение и активную деятельность, вирусам необходимы живые клетки организма. Различные вирусы отдают предпочтение строго определенным клеткам. Например, вирус гриппа любит клетки гортани, вот почему это заболевание не обходится без боли в горле.
Также стоит заметить, что вирусы, внедряясь в живые клетки, меняют их структуру таким образом, что они сами начинают размножать патогенную микрофлору и лишаются возможности функционировать правильно.
medic-03.ru
Виды стрептококков в горле — гемолитический и зеленящий, пиогенный и негемолитический и др. 2019
Стрептококк, пожалуй, одна из самых известных бактерий. Многие наслышаны об опасности этого микроорганизма, его способности вызывать серьезные болезни и давать тяжелые осложнения на почки, сердце и суставы. Именно поэтому диагноз «гемолитический стрептококк в горле» звучит устрашающе. Действительно ли стрептококк так опасен? Чем отличается гемолитический стрептококк от негемолитического? Что такое «зеленящий стрептококк? Если вы хотите узнать ответы на эти вопросы, данная статья для вас.
Содержание статьи
Стрептококк — род бактерий, объединяющий множество видов, которыми различаются патогенностью для человека, устойчивостью к лекарствам, биохимическими и генетическими особенностями. При этом все они — паразиты, которые могут существовать в горле, носовой полости, нижних дыхательных путях и желудочно-кишечном тракте. Поговорим подробнее о видах стрептококков и их опасности.
Стрептококк — особенности микроорганизма
Стрептококки, как и другие бактерии-кокки, имеют шаровидную форму клеток. Размножаются они путем простого деления надвое.
Стрептококк — бактерия, постоянно циркулирующая в человеческих популяциях. Этот микроорганизм достаточно долго может сохраняться в воздухе, каплях жидкости, но лучше всего он себя чувствует внутри человеческого тела. Оптимальная температура для его размножения находится в диапазоне 35-37°С, что соответствует показателям термометрии здорового (а также слегка заболевшего) человека.
При температуре выше 38°С жизнедеятельность стрептококка угнетается, однако он может выживать при повышении температуры вплоть до 60°С.
Стрептококк может долгое время храниться в засохшем гное и вязкой мокроте, покрывающей слизистую дыхательных путей. Благодаря этому стрептококк может быть причиной хронических инфекций.
Распространение инфекции происходит при контакте здорового человека с больным — при разговоре, поцелуях и т.п. Такой путь передачи называют воздушно-капельным. Установлено, что бактерия также может передаваться алиметарным (пищевым) и контактно-бытовым путем (при пользовании общей посудой, полотенцами и т.д.).
Стрептококковая инфекция может вызывать такие болезни горла, как:
- банальная ангина;
- хронический тонзиллит;
- скарлатина;
- острый или хронический фарингит.
Классификация стрептококков. Какими они бывают?
Общепринятая классификация стрептококков основана на особенностях роста данных бактерий в культуре (т.е. в лабораторных условиях). Стрептококк выращивают на особой питательной среде — кровяном агаре. Помимо прочих компонентов, кровяной агар содержит эритроциты — красные клетки крови.

В зависимости от того, разрушает ли стрептококк эритроциты, выделяют следующие его группы:
- Альфа-гемолитические стрептококки. Представители данной группы разрушают клетки крови, вызывая окисление гемоглобина. При окислении гемоглобин становится зеленым, поэтому альфа-гемолитический стрептококк нередко называют «зеленящим». Наиболее распространенным представителем зеленящих стрептококков является Streptococcus viridans. Он представлен в большом количестве на коже, слизистых оболочках рта, дыхательных путей, половых органов. Данный микроорганизм является представителем нормальной микрофлоры. Для здорового человека Streptococcus viridans неопасен, но при снижении иммунитета он может вызвать воспаление.
Альфа-гемолитические стрептококки зачастую вызывают бактериальные осложнения простуды и гриппа. В частности, они могут спровоцировать бактериальное осложнение вирусного тонзиллита или фарингита.
В редких случаях альфа-гемолитический стрептококк дает осложнения на сердце.
Именно представители БГСА способны вызвать острый и хронический тонзиллит, фарингит, скарлатину.
- Бета-гемолитические стрептококки. При выращивании на кровяном агаре вызывают гемолиз (т.е. разрушение эритроцитов). Именно бета-гемолитические стрептококки наиболее опасны для человека. Бета-гемолитические виды стрептококков в горле вызывают острое воспаление, которое сопровождается бурным иммунным ответом. В рамках данной группы выделяют 20 серогрупп (обозначаются буквами латинского алфавита, от А до О), в зависимости от биохимических особенностей бактерий. Наибольшее медицинское значение имеют серогруппы А и В:
- Бета-гемолитический стрептококк группы А (в медицине часто используется аббревиатура БГСА)– возбудитель большинства стрептококковых болезней.
- Бета-гемолитический стрептококк группы В (БГСВ) — может быть обнаружен на коже и слизистых здоровых людей. При снижении иммунитета данный микроорганизм может спровоцировать развитие воспаления легких, почек, кишечника, мозга. Особенно опасен БГСВ для беременных женщин.
- Гамма-гемолитические стрептококки. Не вызывают разрушение эритроцитов при выращивании в культуре. Представители данной группы обитают в ротовой полости, кишечнике. В норме не способны нанести вред организму.
Чтобы точно определить, какой именно стрептококк вызвал болезнь горла, необходимо сдать анализ мазка из зева. Врач-лаборант, выращивая бактерии на кровяном агаре, определит, присутствуют ли в горле стрептококки, и к каким группам они относятся. Если требуется более точное определение (до вида) рекомендуется сдать ПЦР-анализ мокроты, основанный на определении ДНК микроорганизма.
Стрептококковые болезни горла
Распространенными заболеваниями горла, которые вызваны стрептококковой инфекцией, являются ангина, фарингит и скарлатина.
Интересно, что стрептококковая инфекция, в первую очередь БГСА, зачастую поражает небные гланды и глотку одновременно, вызывая тонзиллофарингит.
Тонзиллофарингит — высоко контагиозное заболевание. Первые его симптомы проявляются через 24-48 часов после контакта с носителем инфекции. Особенно высока вероятность передачи инфекции от человека, страдающего острым тонзиллитом.
Начало болезни острое, внезапное. Температура тела резко поднимается до 38-39°С (у детей могут быть и более высокие показатели). Больной страдает от головной боли, тошноты, выраженной слабости. У детей часто наблюдается рвота, нарушение пищеварения, боль в животе. Причина этого — интоксикация. Лимфатические узлы на шее увеличиваются, их ощупывание вызывает боль.

Один из наиболее ярких симптомов тонзиллофарингита — боль в горле. Она беспокоит больного практически постоянно, усиливается при глотании, разговоре, кашле и т.п.
При осмотре горла заметно сильное увеличение миндалин, покраснение зева (миндалин, мягкого неба, глотки). Поверхность слизистой оболочки бугристая, отекшая. На миндалинах обычно присутствует гнойный налет. При попытке его снять он легко сдвигается, не вызывая кровотечения (отличие от дифтерии). Отличием от скарлатины является отсутствие каких-либо высыпаний на коже и слизистой оболочке ротовой полости.
Симптомы достигают пика на 2 день болезни, далее постепенно идут на спад (при должном лечении). Болезнь проходит в течение 5-10 дней. Лимфатические узлы могут восстанавливаться немного дольше (до 14 дней).
Стрептококковый тонзиллофарингит склонен к переходу в хроническую форму. В таком случае наблюдается периодическое обострение ангины и фарингита.
В чем опасность стрептококковых инфекций?
Главное, что необходимо знать о стрептококковой инфекции — она способна вызывать развития тяжелых осложнений. В первую очередь это касается БГСА — наиболее распространенного и опасного возбудителя.
Стрептококковые заболевания горла, такие как ангина и фарингит, можно вылечить за неделю. Если же запустить болезнь, начинают развиваться осложнения — ревматоидный артрит, гломерулонефрит и др.
Такие осложнения приходиться лечить годами. Именно поэтому вопрос о правильном лечении стафилококковых инфекций требует особого внимания.
Терапия стрептококковых инфекций, в том числе тонзиллофарингита, в обязательном порядке включает прием антибактериальных препаратов системного действия (антибиотиков в виде таблеток или инъекций). При отказе от антибиотикотерапии существенно возрастает вероятность развития осложнений, что доказано многочисленными медицинскими исследованиями. Конечно, осложнения развиваются не у всех, но рисковать не стоит. Когда на одной чаше весов — незначительные побочные эффекты антибиотиков, а на другой — тяжелые последствия отказа от них, выбор очевиден.
Перечислим осложнения, которые может вызвать БГСА:
- острая ревматическая лихорадка;
- ревматическая болезнь сердца, поражающая клапаны и стенку сердца;
- постстрептококковый гломерулонефрит, проявляющийся в воспалении почечных клубочков;
- ревматоидный артрит (воспаление суставов).

Такие осложнения обычно развиваются через 2-3 недели после выздоровления. Все вышеуказанные заболевания существенно снижают качество жизни и тяжело поддаются лечению.
Как и почему развиваются постстрептококковые осложнения? Первый механизм — воздействие токсинов, выделяемых бактерией. Особый вред стрептококковые токсины наносят сердцу. Второй механизм более сложный. Дело в том, что белки клеточной стенки стрептококка по своей структуре напоминают некоторые белки тела человека, входящие в состав сердечной мышцы, клапанов сердца, почечных лоханок, суставных поверхностей. Если стрептококк задерживается в организме слишком долго (например, при хроническом тонзиллите, затяжном фарингите), иммунная система начинает активно уничтожать все, что напоминает по строению клетку стрептококка. В результате вырабатываемые антитела разрушают не только вредоносную бактерию, но и собственные клетки организма.
Таким образом, стрептококковая инфекция способна запускать в организме аутоииммунные реакции.
Лечение стрептококковой инфекции горла
Основа лечения стрептококковых инфекций, вызванных БГСА — антибиотики. Своевременный прием антибиотиков не только приводит к быстрому исчезновению симптомов болезни, но и предупреждает развитие осложнений, в том числе ревматических.
БГСА обладает высокой чувствительностью к пенициллинам, цефалоспоринам и макролидам. Препаратами первого выбора являются пенициллины. Препараты Феноксиметил-пенициллин и Амоксициллин принимают трижды в день, по 500 мг (т.е. 1,5 г в сутки). Уточните дозировку у лечащего врача. Она может варьировать в зависимости от возраста больного и тяжести инфекции. При непереносимости пенициллина врач может назначить макролиды — эритромицин, азитромицин, кларитромицин. Схемы лечения данными препаратами назначаются индивидуально.
Препараты гентамицин, тетрациклин и канамицин малоэффективны по отношению к бета-гемолитическому стрептококку группы А. Назначать их при ангине нецелесообразно.
Стандартный курс лечения стрептококковой инфекции — 10 дней. Исключение — азитромицин (курс лечения данным препаратом составляет 5 дней). При этом улучшение наблюдается уже на 2 сутки лечения. В этот момент важно не прекращать лечение. Для полного уничтожения очага инфекции необходимо полностью пройти курс.
Через 2 недели после выздоровления рекомендуется сдать бактериологические анализы, подтверждающие отсутствие стрептококковой инфекции в организме.
Автор: Оксана Циклаури
Источники: medscape.com, health.harvard.edu, medicalnewstoday.com.
basket-parts.ru
как передается, медикаменты, показатели, у взрослых
Клебсиелла: лечение, в кишечнике, симптомы, в кале и в моче у взрослых

Многие годы пытаетесь избавиться от ПАРАЗИТОВ?
Глава Института: «Вы будете поражены, насколько просто можно избавиться от паразитов принимая каждый день…Читать далее »
Клебсиелла является микроорганизмом условно-патогенным из семейства Enterobacteriaceae. Микроорганизм способен вызывать инфекционные заболевания различного типа, а также тяжелые септические проявления, тяжесть последствий жизнедеятельности клебсиеллы зависит от состояния иммунной системы у конкретного пациента.
- Что такое клебсиелла
- Причины возникновения инфекции
- Симптомы инфекции
- Осложнения при клебсиелле
- Диагностика
- Лечение клебсиеллы
Что такое клебсиелла

Клебсиелла представляет собой грамотрицательные палочки на микробиологическом уровне (окрашивание по Граму не дает специфического фиолетового оттенка), микроорганизмы имеют размеры 1,0 х 6,0 мкм. Палочки неподвижны, могут располагаться и в одиночку, и попарно, кроме того, клебсиеллы нередко выстраиваются в цепочку.
НАШИ ЧИТАТЕЛИ РЕКОМЕНДУЮТ!
Для избавления от паразитов наши читатели успешно используют Intoxic. Видя, такую популярность этого средства мы решили предложить его и вашему вниманию.
Подробнее здесь…
Клебсиелла принадлежит к классу факультативных анаэробов, эти организмы имеют способность размножения при условии отсутствия кислорода, но и при его наличии своей жизнеспособности они не теряют. Имеют О-антигены и К-антигены, по которым и происходит их отличие внутри рода.
В физиологических нормальных условиях клебсиелла не является чем- то патологическим – микроорганизм входит в состав нормальной флоры системы пищеварения, также и кишечника. К примеру, норма содержания бактерии в кале не должна быть более 105 клеток микробных на один грамм испражнений. Кроме кишечника, подобный микроорганизм в незначительном количестве может присутствовать на кожном покрове, слизистой оболочке путей дыхания. Свою жизнеспособность клебсиелла сохраняет в почве, пыли, воде, пищевых продуктах, микроорганизм даже обладает способностью размножаться в продуктах, которые находятся в холодильнике.
Причины возникновения инфекции
Источником инфекции у взрослых и детей является сам человек, уже зараженный клебсиеллезной инфекцией. В кишечник палочка попадает при недостаточном соблюдении правил гигиены, грязные руки, употребление грязных фруктов и овощей – все это возможности заражения клебсиеллой. Факторами передачи выступают продукты питания, наиболее часто это молочные и мясные продукты, фрукты и овощи.
Если у больного наблюдается пневмония, то инфицировать окружающих он может воздушно-капельным путем. Восприимчивость к инфекции имеет всеобщий характер, однако выделяют группу риска, в нее входят:
- Новорожденные и дети грудного возраста.
- Пожилые люди с иммунодефицитом.
- Пациенты, имеющие такие заболевания, как сахарный диабет, болезни крови, онкологические болезни.
- Пациенты после пересадки тканей и органов.
- Пациенты, страдающие алкоголизмом хронического типа.
В кишечнике человека клебсиелла производит эндотоксин, образование которого происходит в результате разрушения микроба, это является главной причиной возникновения реакции инфекционно-токсического типа.
Кроме эндотоксина, микроорганизм вырабатывает термостабильный энтеротоксин и мембранотоксин, первый вызывает поражение слизистой кишечника и жидкий водянистый стул, второй обладает активностью гемолитической и поражает клетки.
Симптомы инфекции

После заражения инфекционным микроорганизмом наступает инкубационный период, длительность которого может затянуться на несколько часов или на несколько дней. По его окончанию, клебсиелла дает о себе знать довольно яркими симптомами, которые проявляются в зависимости от локации поражения.
Если произошло поражение легких (пневмония клебсиеллезная), у больного могут наблюдаться симптомы:
- Потливость, озноб, слабость.
- Лихорадка, температура колеблется между 37,5 и 39 градусов.
- Сухой кашель, на смену которому приходит мокрота гнойного характера с примесями крови, а также неприятным запахом.
- Сильная одышка.
- Ослабление дыхания с воспаленной стороны, обнаруживается при прослушивании легких. Влажные и сухие хрипы, перкуторный звук притупляется при простукивании.
- При рентгенографии обнаруживается склонность к слиянию очагов инфильтрации в долях легких.
Если лечить клебсиеллезную пневмонию вовремя, шансы на выздоровление довольно высокие, однако при отсутствии своевременного лечения возникает распространение инфекции, развитие получает сепсис.
Если клебсиелла поражает верхние дыхательные пути и слизистую оболочку носа, отмечают следующие симптомы:
- Развитие риносклеромы – образование гранулем на оболочке верхних дыхательных путей и носа. В самих гранулемах локализуются микроорганизмы, это провоцирует заложенность носа, обильные выделения слизисто-гнойного характера со специфическим запахом.
- Развитие хронической болезни носоглотки и трахеи, характеризуется атрофией слизистой носа и костей носа, выделениями гнойного секрета, зловонным запахом, корочками на поверхности слизистой, першением в горле, кашлем со слизью.
Какие симптомы обнаруживаются при поражении желудочно-кишечного тракта:
- Проявления острого гастрита – болевые ощущения в животе, приступы тошноты, сниженный аппетит, изжога.
- Развитие острого энтерита либо энтероколита при поражении кишечника.
- Температура тела разной выраженности.
- Жидкий стул, в кале может присутствовать кровь, слизь, все это сопровождается зловонным запахом.
При наличии микроорганизма в моче наблюдаются такие симптомы, как:
- Бесконтрольная раздражительность.
- Развитие пиелонефрита, также бактерии в моче провоцируют цистит и простатит.
Если клебсиелла находится в моче, может быть болезненность при мочеиспускании, возникает боль тупого характера внизу живота. Также бактерии в моче вызывают мочеиспускание маленькими порциями.
Осложнения при клебсиелле
При тяжелых проявлениях инфекции, таких как пневмония и сепсис, нередко развитие получают серьезные осложнения:
- Инфекционно-токсический шок.
- Отек легких.
- Отек головного мозга.
- Геморрагический синдром.
После перенесенной клебсиеллы в значительной степени ослабляется иммунитет, может быть рецидив.
Диагностика
После обнаружения симптомов клебсиеллы необходимо проведение диагностики. Кроме сбора анамнеза диагностические мероприятия включают в себя лабораторные исследования, которые заключаются в обнаружении микроорганизма в кале, моче, мокроте, ротовой полости, слизи носоглотки, спинномозговой жидкости, желчи. Выбор материала для исследования зависит от клинических проявлений болезни.
Методы исследования:
- Бактериоскопия – окрашивание по Граму.
- Посев материала на питательные среды.
- Серологические методы.
Могут быть проведены дополнительные анализы для обнаружения бактерии в крови, моче, пациенту может быть назначена копрограмма.
Лечение клебсиеллы

После проведения диагностики врач определяет, как лечить инфекцию. Тактика лечения зависит от формы заболевания, тяжести его проявления. Если клебсиеллой был поражен кишечник, а инфекция протекает в легкой форме, лечение назначают амбулаторное с применением бактериофагов и пробиотиков.
Лечить клебсиеллу бектериофагами нужно следующим образом: прием препаратов осуществлять до еды 3 раза в день. Однократные дозы: для детей до шести месяцев – 5 миллилитров, для детей от 6 месяцев до 1 года – 10 миллилитров, для детей одного — трех лет – 15 мл, для детей трех -семи лет – 20 мл, для детей от 8 лет и для взрослых – 30 мл.
Лечить клебсиеллу можно такими пробиотиками, как Пробифор, Бифидумбактерин, Аципол, Бифиформ, Ацилакт, Линнекс, Бифилонг, Примадофилюс, Биовестин. Курс приема должен длиться не менее десяти дней, оптимальное лечение будет занимать 14-21 день. Дозировку врач назначает индивидуально.
При поражении клебсиеллой других систем, а также при тяжелых проявлениях инфекции лечить ее необходимо в стационарных условиях. На период лихорадки назначается постельный режим, а также специальная диета и обильный питьевой режим при интоксикации.
Пациенту может быть назначена этиотропная терапия с использованием антибактериальных препаратов, используют полусинтетические пенициллины, аминогликозиды, цефалоспорины, тетрациклины, в некоторых случаях возможен прием фторхинолонов.
Лечение клебсиеллы может быть дополнено патогенетической терапией, действие которой заключается в снижении лихорадочного синдрома и интоксикации, а также в профилактике развития возможных осложнений.
Профилактические мероприятия по предотвращению развития клебсиеллезной инфекции сводятся к гигиеническому воспитанию детей, своевременному лечению хронических инфекций и заболеваний, а также к укреплению иммунной системы. Будьте здоровы!
источник
Симптомы при паразитах
Заражение организма паразитами может настигнуть любого человека. Существует огромное количество разновидностей паразитов, среда их обитания весьма обширна: они могут обитать в воде, земле, продуктах питания, организмах домашних животных и других местах, порой весьма неожиданных. Симптомы при заражении паразитами могут проявляться головной болью, неприятными ощущениями в области живота, тошнотой, повышением температуры тела. Итак, сегодня мы поговорим о паразитах в организме человека, о симптомах заражения и способах выведения паразитов из организма.
Что такое паразиты
Это животные, растения или микроорганизмы, которые живут за счёт своего хозяина. Они питаются его клетками или тканями, используют витамины и питательные вещества, которые должны были пойти на постройку клеток тела хозяина. Паразиты также отравляют организм веществами, которые выделяют в процессе своей жизнедеятельности.
В медицине паразитами человека называют только многоклеточных и простейших, а вирусы и бактерии относятся к возбудителям болезней. Рассмотрим, какие бывают паразиты в организме человека, симптомы их присутствия и лечение народными средствами.
От паразитов в человеческом организме не застрахован никто. Чтобы заразиться ими хватит несколько секунд, а вот избавиться непросто. И у детей, и у взрослых заболевание прогрессирует очень быстро. Оно сопровождается болящими симптомами и приводит к полной потере сил. От глистов существуют разные народные средства, приготавливаемые в домашних условиях при минимальных затратах.
Как паразиты попадают в организм человека
В организм человека они попадают разными путями, чаще всего это связано с употреблением заражённой воды и пищи.
НАШИ ЧИТАТЕЛИ РЕКОМЕНДУЮТ!
Для избавления от паразитов наши читатели успешно используют Intoxic. Видя, такую популярность этого средства мы решили предложить его и вашему вниманию.
Подробнее здесь…
Паразиты проникают внутрь нас с укусами насекомых, при купании в пресноводных водоёмах, через воздух, с пылью, которая является переносчиком яиц. Собаки и кошки, через своё влажное дыхание, могут рассеивать яйца паразитов на расстоянии до 5 метров. Яйца остриц сохраняют жизнеспособность до 6 месяцев и через игрушки, ковры, нательное и пастельное бельё попадают в организм.
Яйца аскариды попадают к нам внутрь через плохо вымытые овощи и фрукты. Шашлык или домашнее сало — это 95% гарантия заражения трихинеллёзом. Солёная рыба, строганина или икра являются причиной заражения ленточным червем, длинна которого достигает 12 метров и который может прожить у вас в организме до 25 лет. Участились случаи заражения младенцев паразитами ещё в утробе матери.
Можно заразиться через грязные руки, не только свои, но и продавцов, поваров, официантов, яйца паразитов путешествуют на деньгах и поручнях общественного транспорта. Высокая концентрация яиц паразитов наблюдается в продуктах, таких как: бекон, копчёная колбаса, ветчина, сосиски, свинина любых форм, говядина, курятина, баранина, и даже куриные яйца очень часто заражены ими. Эпидемиологи всего мира пытаются бороться с этой напастью.
В США например, для проверки на гельминтоз уничтожают 1 свиную тушу из каждой тысячи. Это складывается в многомиллионные убытки, но иначе нельзя. Абсолютно надёжных способов обеззараживания мяса нет, а обычная кулинарная обработка личинок не уничтожает.
Вы не можете гарантировать себе чистоту своей пищи, сварив или обжарив мясо, огромное количество личинок паразитов всё равно проникает в ваш организм. Основные пути попадания паразитов в организм человека:
- через заражённую еду и воду. Причём в некоторых случаях она загрязняется в процессе хранения, приготовления, этому также способствуют мухи, тараканы. А иногда пища может быть заражена изначально, например, при использовании для приготовления еды термически плохо обработанной рыбы, мяса заражённых животных;
- контактно-бытовой путь, это когда паразиты передаются от одного человека к другому, через предметы быта или домашних животных;
- трансмиссивный путь, когда паразиты переносятся кровососущими насекомыми.
Воздействие паразитов на организм
Паразиты в теле человека нарушают работу органов, вызывают в них воспалительные процессы, разрушают ткани. Часто в процессе своей жизнедеятельности паразиты вырабатывают вещества токсичные для человека, что приводит к постепенному отравлению его организма.
Паразиты хорошо приспосабливаются, способны годами жить в одном организме, а их яйца и личинки обладают значительной устойчивостью к окружающей среде. В органах пищеварения для своей защиты паразиты могут выделять специальные вещества, которые инактивируют ферменты, нарушают процесс переваривания пищи. Поэтому у больного с паразитами в кишечнике, симптомы часто напоминают заболевания пищеварительной системы.
Основные симптомы присутствия паразитов в человеческом организме
Основными симптомами присутствия паразитов в человеческом организме являются следующие:
- запоры: обильная глистная инфекция может заблокировать желчные и кишечные пути, что приводит к редким и затрудненным испражнениям;
- понос:ряд паразитов производят простагландин, ведущий к потере натрия и хлоридов, что приводит к частым водянистым испражнениям. Таким образом понос при паразитарной инфекции является функцией паразита, а не попыткой организма избавится от инфекции;
- газы и вздутие: ряд паразитов проживает в верхней тонкой кишке, где вызванное ими воспаление приводит к вздутию и газами;
- боли в суставах и мышцах: паразиты могут мигрировать с целью инкапсулирования в суставной жидкости и в мышцах. При этом человек испытывает боли, которые часто считают признаком артрита. Боли и воспаления суставов и мышц являются также результатом травмирование тканей, причиненного паразитами либо иммунной реакцией организма на их присутствие;
- аллергия: паразиты могут раздражать, а иногда и пробивать оболочку кишок, что ведет к попаданию в кровь крупных молекул непереваренной пищи. Это активизирует иммунную систему и вызывает аллергическую реакцию. Сами по себе паразиты тоже могут являться аллергенами;
- проблемы с весом: ожирение как следствие глистной инвазии – это результат ограбления организма человека. Из-за прожорливости гельминтов возникает дефицит питательных веществ при избытке «пустых калорий»;
- нервозность: отходы обмена веществ и токсины паразитов могут очень серьезно влиять на нервную систему. Беспокойство, депрессивное состояние, нервозность являются следствием систематического отравления;
- хроническая усталость: симптомы хронической усталости- слабость, апатия, гриппоподобные состояния, депрессия, снижение концентрации, плохая память. Эти симптомы могут быть вызваны паразитами, которые поглощают большую часть питательных веществ. Даже при очень хорошем питании образуется дефицит белков, жиров, углеводов, витаминов и минералов. Усугубляется состояние постоянным отравлением организма;
- иммунные нарушения: паразиты ослабляют иммунную систему, понижая выделение иммуноглобулина. Их присутствие постоянно стимулирует реакцию системы и может ослабить этот жизненно важный механизм, открывая путь проникновения, бактериальных и вирусных инфекций;
- воспаление дыхательных путей: ряд гельминтов мигрирует по организму человека, включая и дыхательные пути. Кашель, повышенная температура, насморк – реальные симптомы присутствия в организме «незваных гостей». Пневмония является одним из проявления аскаридоза;
- плохая кожа: кишечные паразиты могут вызвать крапивницу, сыпи, экзему и другие кожные реакции. Язвы кожи, опухоли, папилломы и прочее могут быть результатом присутствия простейших организмов;
- онкологические заболевания: хроническое отравление организма, сбой в иммунной системе, прямое травмирующее действие на ткани и органы, длительное воспаление и дефицит питательных веществ – этого более чем достаточно для провокации развития опухолей;
- другие симптомы: очень разнообразны и зависят от вида паразита, длительности заражения и степени поражения органов. Диапазон – от мигрени и сердечных приступов до астмы и воспаления мочевыводящих путей.
Все вышеперечисленное – лишь малая часть примеров пагубного воздействия паразитов. В ходе своей жизни человек контактирует с огромным количеством вредоносных микроорганизмов, заражаясь ими. Причем попадание паразитов в организм не в полной мере зависит от вашей чистоплотности. Можно вкусно пообедать в дорогом ресторане, съесть салат с зеленью, и иметь все шансы заболеть аскаридозом.
Признаки паразитов в организме
- Причиной появления астмы нередко является паразит сосальщик, «проживающий» в печени человека.;
- у людей, страдающих раком, желудочно-кишечный тракт зашлакован сухими каловыми отложениями, а они служат привлекательной средой для паразитов;
- от недостатка кремния, который «пожирают» червяки, в организме человека могут развиваться такие заболевания как экзема и псориаз;
- редкие испражнения могут возникнуть от обильной глистной инвазии, которая блокирует желчные и кишечные проходы, что и служит причиной появления запоров;
Все думают, что диарея — это способ избавления от инфекций в организме или следствие съеденных некачественных продуктов. Как правило, так оно и есть, но и случается, что симптомы частых водянистых испражнений являются функцией червяков, вырабатывающие гормоноподобные вещества, ведущие к потере натрия и хлоридов;
- в следствии поиска более удобных мест для обитания, а следовательно перемещений паразитов по организму могут появиться суставные и мышечные боли, которые нередко списывают на артрит. Привлекательная среда для них — суставная жидкость и мышцы;
- из-за раздражения паразитами оболочек кишечника, возникает вероятность проникновения в них не усвоенных молекул. В результате этого организм включает защитную функцию, которая проявляется как производство защитных клеток — эозинофилов. Они вызывают воспаление тканей, а это, в свою очередь, приводит к аллергии;
Присутствие червячков в кишечнике может стать причиной появления многих кожных заболеваний; импотенция — следствие питания трихомонады сперматозоидами; плохой сон, пробуждения среди ночи, как правило, в 2-3 ч, могут послужить сигналом присутствия паразитов, от которых организм избавляется при помощи печени;
- хроническая усталость и ослабление иммунитета также могут быть симптомами присутствия инородных жителей; рассеянный склероз является болезнью спинного и головного мозга. Ученые установили, что причиной данного заболевания могут послужить трематоды, достигающие головного и спинного мозга и размножающиеся там. Эти паразиты попадают в организм человека вместе с молочными продуктами. Они так же вызывают депрессивное состояние и раздражительность.
Какие паразиты живут в печени человека
Печень — это резервуар для скопления, размножения и среды обитания различных микроорганизмов. Причина кроется в том, что данный орган не имеет защиты от них. В печени происходит активный обмен веществ, с чем связано частое появление паразитов в этом жизненно важном органе. Также в клетках паренхимы печени содержится много питательных веществ, что тоже влияет на размножение паразитов.
Дальнейшему заселению микроорганизмов способствуют и особенности кровообращения в данном органе. Со временем личинки паразитов достигают размеров зрелых особей, которые способствуют развитию эхинококковой кисты, вызывающей множество различных заболеваний. Виды паразитов, живущих в печени:
- амёбы: амёбы проникают через стенку кишечника в лимфатические узлы и вены, по которым перемещаются к печени. Они опасны тем, что способствуют формированию тромбов, нарушают питание клеток, выделяют нежелательные продукты жизнедеятельности. В результате в печени образовываются некрозы, соединяющиеся впоследствии в большой очаг поражения. Это называется амёбным абсцессом;
- лямблии: если в печени обнаружены лямблии, то речь идёт о лямблиозе. Опасность данных паразитов в том, что они способены провоцировать возникновение дистрофии клеток печени, вызывать воспалительные процессы. При присоединении к лямблиозу дополнительной бактериальной инфекции количество лейкоцитов в крови увеличивается;
- альвеолярный эхинококк; может поразить как клетки, так и ткани печени. Во многих случаях метастазы распространяются и в другие органы, например, в лёгкие и центральную нервную систему. Паразит относится к ленточным червям – цестодам;
- шистосомы: паразитируют в кровеносных сосудах печени. Яйца паразита проникают в ткани печени. Если орган поражён, то возможен гепатит и цироз печени;
- однокамерный эхинококк: относится к цестодам, напоминающим пузырь. Способен активно увеличиваться, вследствие чего происходит атрофия тканей печени, сдавливание сосудов и желчных протоков;
- аскарида: это круглый паразит, который, проникнув в печень, вызывает микроабсцессы и микронекрозы. Если в органе поселяются уже взрослые особи, то человек заболевает холангитом или гепатитом, возникает большая вероятность воспалительного гнойного процесса.
Паразиты в горле человека
Отвечая на вопрос могут ли паразиты жить в горле, можно с уверенностью ответить, что нет. Все симптомы, которые проявляются в гортани, это следствии того, что червь паразитирует в легких или печени, что значительно снижает защитные функции организма человека. Боль, ощущение комка в гортани, слюна становится очень густой, гнойники и воспаления десен как на фото — все эти симптомы являются прямыми показателями для проведения диагностики на наличие гельминтозного заболевания.
Первоочередное лечение заболевания паразитами можно проводить самостоятельно в домашних условиях. Можно воспользоваться следующими народными методами лечения от глиста: употребление чеснока: глист не выносит пряных овощей или трав; содовые полоскания гортани: на 200 мл кипятка разводятся 1 ч.л. соды и 3 капли йода. Полоскать 3 раза в день.
Паразиты в кишечнике у человека
Какие паразиты живут в кишечнике? Организм заражается не одним и не двумя, а несколькими различными видами глистов. Они могут сосуществовать в кишечнике одновременно, но чаще глисты у человека встречаются по отдельности. Основная классификация червей – по их внешнему виду. Паразиты кишечные, симптомы имеют похожие. Основных видов червей три: ленточные; плоские; круглые.
Ленточные черви в кишечнике отличаются сегментированным телом и полуплоской формой, из-за которой гельминты и получили свое название (см. фото). Круглые паразиты в кишечнике человека выглядят наиболее приближено к стандартному дождевому червю. Они полупрозрачные, с белым или бесцветным телом, сквозь которое просвечивает основной сосуд.
Плоские черви обычно обладают овальной формой, изредка они слегка сегментированные. Длина любого типа может достигать от 10 мм до 10 метров. Существует множество различных паразитов в тонком кишечнике, некоторые из них имеют размеры намного меньше.
Специалисты выделяют всего более 10 видов глистной инвазии, которые основаны на различных возбудителях. Самый распространенный тип – аскаридоз, то есть заражение аскаридой длиной от 15 до 40 см с характерными болями в животе и интоксикацией. Но есть и другие варианты:
- трихоцефалез: возбудитель – власоглав. Власоглав – один из самых универсальных глистов. Он проникает и в слепую кишку, и в толстый и тонкий кишечник. В качестве основных симптомов выделяются головокружение, рвота, тошнота и другие признаки глистов и интоксикации. Паразиты, проживающие в тонком кишечнике, легко выводятся препаратами;
- тениаринхоз: это процесс развития бычьего цепня в организме человека. Этот червь передается через мясные продукты и крупных домашних животных. В результате возникает постоянная интоксикация организма и боли в брюшной полости;
- метагонимоз: одна из самых опасных форм паразитов в кишечнике человека, требующая срочного выведения. Она вызывается сосальщиками, способными привести к воспалению кишечника. Заражение происходит через необработанную рыбу;
- трихиннелез: самая тяжелая форма, приводящая к смерти пациента при длительном отсутствии терапии. Возбудитель – трихинелла, — может проникнуть из кишечника во внутренние органы и серьезно нарушить их работу. Из-за повышенной активности паразита боли ощущаются не только в животе, но и в мышцах. Как аллергическая реакция – начинается конъюнктивит.
Профилактика заражения паразитами
Паразитной инвазии легко избежать при помощи простой гигиены. В первую очередь специалисты рекомендуют ограничить контакт с непроверенными животными и улучшить гигиену питания. Любые овощи, фрукты, зелень, обязательно нужно мыть. На их поверхности могут быть незаметные человеческому глазу личинки гельминтов. Мясо при жарке нужно доводить до состояния готовности, при этом убивая возможных паразитов. Важно соблюдать правила личной гигиены:
- щетка, которой осуществляется чистка зубов, должна быть у каждого отдельная;
- то же касается и полотенец для тела;
- после еды посуду за собой или домочадцами нужно обязательно мыть;
- нельзя есть из чужой грязной тарелки;
- руки необходимо мыть после посещения улицы, контакта с домашним животным и перед едой.
Соблюдение элементарных правил позволит навсегда забыть о проблеме инвазии. В качестве гарантии здоровья можно принимать профилактические составы наподобие «Тройчатка Эвалар». Перед покупкой травяного БАДА, который обеспечит постоянную защиту организма, нужно проконсультироваться с врачом.
Почистить организм полезно и в профилактических целях: это позволяет убрать еще и шлаки при помощи очищающих методик. При своевременной терапии глистная инвазия не представляет опасности.
Источники:
- http://otravleniya.net/ochishhenie-organizma/narodnye-sredstva-ot-parazitov-v-organizme-cheloveka.html
- http://www.nsp.lv/publ/articles/health_and_beauty_healthy_lifestyle_body_nutrition_cleansing/human_parasites_helminths_worms_body_cleaning/7-1-0-158
- https://econet.ru/articles/72723-priznaki-nalichiya-parazitov-v-organizme-proverte-sebya-i-svoih-blizkih
- https://bestlavka.ru/simptomy-i-priznaki-parazitov-v-organizme/
- http://vseopecheni.ru/news/Vidi-parazitov-zhivushih-v-pecheni/
- https://fitohome.ru/bolezni/parazity/parazity-v-gorle-cheloveka-simptomy-i-lechenie.html
- http://protoxin.ru/ochishenie/parazity/parazity-v-kishechnike-u-cheloveka.html
Соблюдение гигиенических правил не всегда гарантирует полную безопасность от заражения глистами. Часто затяжные заболевания носоглотки вызваны гельминтами, которые могут свободно перемещаться по организму. О наличии паразитов в носу многие люди узнают случайно, когда обращаются за консультацией к врачу. Насколько опасны глистные инвазии носоглотки?
Какие гельминты живут в носу
Глистные инвазии – распространенное заболевание, которое негативно сказывается на психическом и физическом состоянии человека. Чаще всего паразиты обитают в органах пищеварительной системы, но некоторые перемещаются по всему организму.
В носу могу поселиться внекишечные гельминты, которые мигрируют в организме – чаще всего это аскариды. В форме личинок эти паразиты проникают во все внутренние органы человека в поисках места для роста и дальнейшего размножения или выхода наружу. Аскариды, которые оказались в носоглотке, начинают питаться тканями слизистой оболочки, что приводит к ее разрушению, появлению сильной отечности.
Важно! Заразиться аскаридозом можно только при употреблении грязных овощей и фруктов – личинки аскарид обитают только в земле.
Аскариды в носу бывают у новорожденных. Если женщина заболела аскаридозом во время беременности, личинки через плаценту попадают в плод. У ребенка могут возникнуть проблемы с дыханием, простудные и вирусные заболевания, сильные аллергические реакции.
Иногда в носоглотку попадают личинки мух, которые крепятся на слизистой носа. В группе риска люди с хроническим ринитом и другими заболеваниями, для которых характерно повреждение слизистой оболочки носа.
Заразиться личинками мух можно в Индии, некоторых странах Южной Америки. При этом у человека начинаются кровянистые выделения из носа, которые имеют неприятный запах серы. Личинки обитают в заднем отделе носовых пазух, а при длительном инфицировании может развиться менингит.
Симптомы
Признаки заражения паразитами носоглотки схожи с ЛОР заболеваниями – хроническая заложенность носа, астма, ларингиты, трахеиты, частые простуды и респираторные заболевания. При этом прием лекарственных препаратов не приносит облегчения и болезни приобретают хронический характер.
Обнаружить глистов в активной форме может ЛОР врач при осмотре пациента. Иногда аскарид можно увидеть самостоятельно – белые черви небольшого размера выходят из носа вместе со слизью или мокротой.

Важно! Не следует пытаться извлечь паразитов самостоятельно – они переместятся внутрь носовых пазух, что приведет к развитию тяжелых заболеваний.
На фоне заражения паразитами происходит ослабление иммунитета, что приводит к образованию полипов, аденом и кист в носовых пазухах. Глистная инвазия может сопровождаться высокой температурой, неприятным запахом из носа или рта.
При наличии паразитов в носу проявляются все признаки заражения глистами – усталость, слабость, насморк, ухудшение сна и аппетита. Инфицированный человек становится излишне возбужденным или апатичным.
Паразиты изначально попадают в ткани лимфоидного кольца носоглотки и полости рта, откуда начинают мигрировать в близлежащие органы.
Чем опасны паразиты в носу:
- сильная головная боль с локализацией в разных областях;
- дышать сложно, нос все время заложен;
- постоянно присутствует зуд и першение в носоглотке, человек может часто чихать;
- возникают внезапные кровотечения из носа.

Аскариды из носоглотки могут переползти в слуховую трубку – у человека возникает звон в ушах, ухудшается слух, кружится голова, развивается морская болезнь.
При отсутствии лечения личинки мигрируют из носоглотки в мозг, лимфатические узлы, что приводит к развитию патологических изменений в этих органах, сильной интоксикации – возможен летальный исход. Наиболее опасные последствия заражения – разрушение костной ткани носа. У человека может произойти деформация переносицы, сильная отечность лица.
Как лечить
При затяжном кашле и насморке необходимо посетить врача-инфекциониста или паразитолога.
Важно! Для диагностики присутствия паразитов в носу сдавать анализ кала бесполезно. Определить глистную инвазию можно при помощи клинического и иммуноферментного анализа крови, рентгена головы.
Лечение паразитов в носу зависит от вида паразита.
Средства для уничтожения личинок мух:
- вещества с сильным запахом – перувианский бальзам, эфир;
- отвары пижмы, полыни – заварить 220 мл кипятка 10 г травы, вдыхать пары до полного остывания жидкости;
- вдувание порошка йодоформ или кальмель;
- раствор сулемы, карболовой кислоты.

Лечение аскарид в носу происходит при помощи лекарственных средств против аскаридоза.
На начальном этапе терапии принимают препараты, которые активизируют выработку желчи – желчные ферменты способны расщеплять сложные структуры аскарид и их личинок. Для устранения паразитов используют противогельминтные препараты широкого спектра действия.
Альбендазол принимают по 1 таблетке раз в сутки на протяжении 5 дней. Через 3 недели курс лекарства нужно принять повторно, поскольку за это время личинки превратились во взрослых особей.
Мебендазол принимают дважды в день по 0,1 г. Продолжительность курса – 2 дня. Через 2–3 недели необходимо пройти повторное обследование.
После гибели паразитов организм необходимо очистить от токсинов и продуктов распада при помощи сорбентов – Смекта, активированный уголь. Для восстановления микрофлоры используют Линекс, натуральные средства с пробиотиками.
Появление глистов из носа скорее исключение, нежели правило. При длительном рините, частых простудах нужно посетить терапевта, ЛОРа, инфекциониста. Самостоятельно принимать противогельминтные препараты нельзя – не каждый их них универсален, но при этом все они токсичны.
aacr.ru
Вирусная или бактериальная ангина: в чем отличие?
Ангина является одним из наиболее распространенных острых воспалительных заболеваний горла. Разобраться в том, что ангина — это вирусное или бактериальное заболевание бывает трудно даже специалисту. Эти болезни имеют отличительные черты, но в то же время очень похожи. Верный диагноз является залогом правильного лечения.
В зависимости от того, какой инфекцией вызвано воспаление миндалин, отличается тактика лечения. А неправильная терапия является одной из причин тяжелого течения и различных осложнений. Именно поэтому столь важно правильно диагностировать и уметь отличать вирусную ангину от бактериальной.
Виды ангин
Начало правильной диагностики и выявления возбудителя это определение вида ангины, которая развилась у больного. Это важно, потому что некоторые виды болезни вызываются в равной степени, как вирусами, так и бактериями. Существуют и чисто вирусные формы этого заболевания.
По клиническому течению ангины бывают:
- катаральная;
- фолликулярная;
- лакунарная;
- герпетическая;
- язвенно-пленочная.
Катаральная ангина

При этом типе ангины воспаление возникает в верхних слоях миндалин и не распространяется вглубь, а нагноения не происходит. Заболевание обычно вызывается стрептококками и ему характерен сезонный характер.
Течение болезни, как правило, нетяжелое, а выздоровление происходит на протяжении 5-7 дней. Боль менее выражена, чем при более тяжелых формах. Температура тела обычно невысокая, а выраженной интоксикации не отмечается. Этот вид достаточно хорошо поддается лечению.
Фолликулярная ангина
Это более тяжелое и длительное заболевание, которое может вызывать серьезные осложнения. При этом заболевании отмечается гнойное воспаление в фолликулах миндалин.
Симптомы воспаления, болевой синдром выражены гораздо сильнее катаральной формы, отмечается сильная интоксикация. Такое воспаление должно лечиться в стационаре.
Фолликулярная ангина обычно вызывается бактериями, как правило, бетта-гемолитическим стрептококком. Чаще это заболевание развивается в осенне-зимний период в связи с переохлаждением и снижением иммунитета.
Лакунарная ангина
Также протекает не менее тяжело, с явным болевым и интоксикационным синдромами. При лакунарной ангине образуются так называемые пробки в виде желтых или белых налетов, которые состоят из бактерий и умерших клеток.
Вызывается бактериями, но нередко и вирусными возбудителями в период эпидемий инфекционных болезней.
Герпетическая ангина
Это непосредственно вирусное заболевание, которые вызывается вирусом Коксаки. Его еще называют герпрангина. Болезнь характеризуется высокой заразностью и ей наиболее подвержены дети в младшем возрасте.
Течение болезни может быть довольно тяжелым. Заболевание требует тщательного лечения, так как ему характерны серьезные осложнения.
Язвенно-пленочная
Одна из самых тяжелых форм заболевания, которая проявляется выраженной интоксикацией организма. Характеризуется выраженным нагноением с разрушением миндалин, при этом изо рта исходит неприятный запах.
При этой форме могут возникать абсцессы и флегмоны шеи, осложнения на почки, суставы и сердце.
Причины возникновения ангины

Основными возбудителями вирусных ангин являются вирусы гриппа и парагриппа, аденовирусы, риновирусы, энтеровирусы.
Бактериальные ангины вызываются стрептококками и стафилококками. Среди них болезнь чаще всего вызывает бетта-гемолитический стрептококк. Эта бактерия становится причиной ангины до 80% случаев.
Возбудитель попадает в организм двумя путями: наружным и внутренним. При наружном инфекция попадает воздушно-капельным путем при чихании, кашле, а также с пищей, при игнорировании гигиены (мытье рук).
При внутреннем заносе инфекции, она попадает в миндалины с током крови из других очагов воспаления в организме.
Факторами риска являются:
- общее и местное переохлаждение;
- высокая влажность, сочетающаяся с низкой температурой;
- снижение местного и общего иммунитета;
- различные острые и хронические инфекционные заболевания;
- воспаление околоносовых пазух;
- врожденная предрасположенность;
- инфекционно-аллергическое воспаление.
Различные вирусы и бактерии всегда, так или иначе, попадают в организм. Но именно при снижении защитных сил организма может развиться ангина.
Симптомы ангины
Изначально нужно убедиться, что у больного развилась именно ангина. Ведь бывает множество других воспалительных заболеваний рото- и носоглотки с похожими проявлениями.
При этом некоторые симптомы общие и проявляются схоже, независимо от возбудителя, а часть из них позволяют более точно определить вирусы или бактерии вызвали болезнь.
Боль в горле один из явных и выраженных симптомов, с которым пациенты обращаются врачу. Боли усиливается во время глотания, особенно твердой и холодной пищи. В наиболее тяжелых случаях, это мешает человеку нормально питаться.
Боль в горле может проявляться как в виде начального небольшого дискомфорта и по мере развития процесса усиливаться все больше. В других случаях, боль выражена в начале болезни.
Отек и покраснение миндалин развивается в результате воспалительного процесса. Степень распространения этого симптома зависит от типа возбудителя.
Лимфатические узлы, как своеобразные фильтры задерживают инфекцию и блокируют ее, а в ответ на это сами воспаляются. Характерно увеличение лимфоузлов в области нижней челюсти, шейных и заушных лимфатических узлов.
Симптомы интоксикации проявляются в виде слабости, сонливости, головной боли, утомляемости, тошноты, рвоты. Этот симптом зависит от стадии и степени выраженность воспалительного процесса.
В некоторых случаях температура тела не достигает высоких цифр, но при гнойном воспалении отмечается довольно выраженная лихорадка. Также резкое и выраженное повышение температуры с первых дней обычно характерно для вирусной ангины, что связано с функции организма по выработке интерферона – особого белка, который борется с вирусами.
Одним из симптомов, непосредственно связанного с колебаниями температуры тела, является озноб. Он возникает в период резкого подъема и спадания температуры.
Вирусная ангина

Одним из типичных признаков ее является сезонный характер. Вирусная ангина обычно возникает во время различных эпидемий, наиболее частой из которых является сезонная эпидемия гриппа.
Характерным отличием является то, что она не имеет определенной локализации. В отличие от бактериального воспаления, при вирусном заболевании воспаляются не только миндалины. Воспаление выходит за пределы небных миндалин на всё горло, мягкое небо и язычок, корень языка.
Для вирусной ангины более характерно острое начало и быстрое развитие. Если в первый же день резко повышается температура тела, появляется острая боль, воспаление, эти признаки могут свидетельствовать о наличии вирусной ангины.
Одной из характерных особенностей является одновременное появление симптомов простуды: насморк, заложенность носа, влажный кашель, ощущение общей разбитости, головная боль.
Слезотечение является одним из симптомов коньюктивита. Появление его в сочетании с ангиной обычно говорит о вирусном заболевании. В этом случае наиболее частым возбудителем является риновирус.
Кашель, который появляется одновременно с ангиной, обычно говорит в пользу вирусной болезни. Он возникает из-за того, что в носу обильно выделяется слизь, которая, стекая в верхние отделы носоглотки и бронхов, раздражает кашлевой центр.
Кашель при вирусной ангине непродуктивный, сухой и болезненный. Больного беспокоят дерущие ощущения в горле. Покашливание не приносит больному облегчения.
Гной и белый налет на миндалинах не всегда является отличительным признаком, но по его виду все же можно делать выводы. Белые очаги, которые распространяются за миндалины, на слизистую горла, небо и покрыты белым налетом, обычно говорит в пользу вирусного поражения.
Одним из типов ангины, которая вызывается непосредственно вирусом, является герпангина. При этом заболевании, кроме типичных признаков, характерно наличие сильной боли в животе, а миндалины и все небо усеяны покрасневшими пузырьками с прозрачной жидкостью.
Это заболевание нуждается в тщательной диагностике и безотлагательном лечении, так как вызывает осложнения в виде менингита, энцефалита, воспаления сердечной мышцы.
Вирусная ангина у детей
У детей возникновение вирусной ангины имеет свои особенности. Так, дети старшего возраста обычно становятся вялыми, слабыми, отмечается сонливость. Маленькие дети, наоборот, обычно становятся капризными, беспокойными.
В детском возрасте ангина сопровождается довольно выраженными симптомами интоксикации. Характерно появление частого кашля из-за обильной слизи из носа.
При энтеровирусной инфекции, которая больше свойственна детям, на миндалинах, дужках, глотке появляются пузырьки с жидкостью. После того как они лопаются, на их месте появляются язвочки с белым налетом.
Заболевание может вызывать грозное осложнение – ложный круп, который приводит к сужению просвета гортани и сильно затрудняет дыхание. Такое состояние является неотложным и требует срочного врачебного вмешательства.
Бактериальные ангины
Для бактериальной ангины общие симптомы простуды, такие как насморк, заложенность носа, слезотечение, не характерны. Бактериальное воспаление обычно развивается местно и больной жалуется только на явления воспаления в горле.
При бактериальном поражении болезнь, как правило, развивается постепенно. В отличие от вирусных форм, начало заболевания проявляется не так резко, а далее по мере ухудшения нарастают характерные симптомы.
Бактериальная ангина обычно локализована. При ней миндалины увеличены, покрасневшие, но за их границы воспалительный процесс обычно не выходит.
Очаги нагноения тоже имеют характерные признаки: имеют белый или желтый цвет, по размеру напоминают просяное зерно с четкими границами. Гнойнички располагаются только на миндалинах.
Белый налет в виде участков, островков на миндалинах указывает на бактериальное заболевание. Исключением является хронический бактериальный тонзиллит. Для него как раз характерно наличие обильного и разлитого белого налета на миндалинах, который может распространяться на ротовую полость.
Для бактериального поражения миндалин не характерно наличие кашля, так как в процесс не вовлекается носовая полость и не выделятся такое обилие слизи, как при вирусной инфекции. Поэтому больной высказывает типичные для ангины жалобы, но при этом кашля нет. Если кашель и возникает, то обычно на поздних сроках болезни в виде осложнений.
Диагностика
Диагноз устанавливается на основе жалоб больного, сбора анамнеза. Доктор уточняет, был ли больной в контакте с инфекционными больными, учитывает сезонность и эпидемическую обстановку.
Отличия вирусной и бактериальной ангины нужны для дальнейшего лечения. Помочь разобраться с тем, что ангина вирусная или бактериальная поможет общий анализ крови. При этом врач по повышению количества определенных клеток крови сможет сделать вывод о возбудителе заболевания. Для вирусной инфекции характерно повышение количества лимфоцитов, а для бактериальной лейкоцитов.
Наиболее точным видом диагностики, который позволяет определить конкретного возбудителя, является взятие мазка из полости глотки для посева. Также при этом заодно определяют чувствительность бактерий к разным антибиотикам, что позволяет назначить эффективное лечение.
Недостатком этого исследования является срок получения результата: на диагностику уходит до нескольких дней.
В домашних условиях можно воспользоваться экспресс-тестом на стрептококк, который продается в аптеках. Метод основан на том, что мазок опускается в специальную жидкость, которая меняет цвет при наличии стрептококка. Однако негативный результат этого теста не исключает наличие других бактерий.
Лечение
Лечение вирусной и бактериальной ангины имеет отличия. Медлить нельзя, так как зачастую это может приводить к различным серьезным осложнениям.
Для лечения бактериального поражения главными являются антибиотики. Ассортимент современных антибактериальных препаратов довольно большой, а процесс выбора конкретного средства ответственный, поэтому лежит в компетенции врача.
При вирусной ангине назначаются противовирусные препараты. Больному показан обязательный постельный режим и избегание физических нагрузок.
Для облегчения симптомов используют также антигистаминные средства, которые снимают воспаление, убирают отек, обладают жаропонижающим и обезболивающим действием.
Важен прием большого количества жидкости, что ускоряет процесс выведения токсинов. К лечению добавляют прием витаминов. При вирусной инфекции особенно важен прием витамина С в достаточных дозах.
Обязательно применяется полоскание горла антисептическими средствами. Для этого используются готовые аптечные препараты, отвары трав, проверенный способ полоскания раствором соли, соды.
В восстановительный период используются физиотерапевтические способы лечения.
Заключение
Клинические проявления разных ангин имеют как свои особенности, так и во многом очень похожи, из-за чего бывает трудно отличить вирусную ангину от бактериальной. Ошибка приводит к неправильному лечению и осложнениям. Поэтому при первых симптомах ангины для правильной диагностики и лечения нужно непременно обращаться к доктору. Именно это является залогом успеха на выздоровление.
prolegkie.com
Как лечить бактериальную инфекцию в горле — proinfekcii.ru
На чтение 8 мин. Просмотров 16
Инфекции в горле – что это?
Вирусная инфекция горла у детей младшего возраста прогрессирует, как правило, тяжело, с высокой температурой, болью при глотании, носовыми выделениями, болью с иррадиацией в уши, раздражающим кашлем, сухостью и жжением слизистых оболочек, что делает горло чувствительным.Боль в горле, инфекция является одним из первых симптомов респираторного заболевания дыхательных путей. Наиболее распространенные причины ангины – бактериальная, вирусная или грибковая инфекция горла, сухой воздух, аллергия, табачный дым и загрязнение воздуха.
Вначале заболевание проявляется ослаблением иммунитета. Горло воспаляется, что является естественной защитной реакцией организма на внешние раздражители: инфекцию, вирусы, бактерии, грибки или механические повреждения.
Вирусные заболевания горла
При вирусной инфекции вирус атакует слизистую оболочку горла и гортани. Вирусное заболевание характерно симптомами иногда мягкими, иногда – более острыми. Вирусная инфекция горла у детей младшего возраста прогрессирует, как правило, тяжело, с высокой температурой, болью при глотании, носовыми выделениями, болью с иррадиацией в уши, раздражающим кашлем, сухостью и жжением слизистых оболочек, что делает горло чувствительным. Выделения вначале бесцветные, постепенно они становятся вязкими, слизистыми и гнойными. Сопровождающие симптомы могут включать головокружение, усталость, потерю аппетита, боли в суставах. Типичное заболевание этого типа – ОРВИ и грипп.
Как распознать бактериальную инфекцию?
Она всегда имеет более серьезный ход, может быть осложнением вирусной инфекции, поражающей горло. Бактериальная инфекция горла, симптомы:
- Очень сильная боль в области шеи, которая может отдаваться в уши.
- Головная боль.
- Повышение температуры выше 38 °С.
- Увеличение лимфатических узлов.
- В случае заболевания у детей ребенок иногда жалуется на боли в животе, может присутствовать рвота.
- Также могут быть осложнения, такие как синусит, отит или менингит. Типичная инфекция, которую вызывает бактерия, представлена стрептококковой ангиной.
Боль в горле может быть не только симптомом простуды, гриппа или ангины. Аналогичным образом проявляется мононуклеоз, гастроэзофагеальная рефлюксная болезнь (изжога), увеличение щитовидной железы, аллергия или даже рак. Если боль в горле сопровождается жаром выше 38 °C или длится дольше, чем неделю, без признаков лихорадки или других симптомов, обратитесь к врачу. Он поможет определить, имеет ли место инфекция горла, и назначит лечение.
Признаки воспаления горла
Основные признаки воспаления:
- Покраснение и жжение в горле.
- Боль в горле, иногда иррадиирующая в уши.
При лечении ангины следует учитывать интенсивность боли и другими проявления инфекции. Боль в горле, как правило, сопровождается симптомами воспаления – покраснением горла, отеком, высокой температурой. - Трудное и болезненное глотание.
- «Царапание», чувство «комка в горле».
- Хрипота и боль во время разговора.
- Увеличенные шейные лимфатические узлы.
- Повышенная секреция слизи.
- Высокая температура, неприятный запах изо рта.
Как лечить ангину
При лечении ангины следует учитывать интенсивность боли и другими проявления инфекции. Боль в горле, как правило, сопровождается симптомами воспаления – покраснением горла, отеком, высокой температурой.
В аптеках в продаже есть спреи, жидкости или пастилки для облегчения симптомов ангины. Эти препараты, как правило, обладают противовоспалительным действием. Некоторые из них – комбинированные, и содержат ингредиенты, которые локально подавляют боль в области шеи.
Противовоспалительный эффект в препаратах направлен на снижение признаков воспаления (отек, покраснение) в области шеи и, тем самым, облегчение глотания.
Обезболивающий эффект – облегчает боль или снимает ее полностью.
У вас болит горло, но в остальном вы чувствуете себя здоровыми?
По всей вероятности, речь идет об инфекционном заболевании верхних дыхательных путей. Боль в горле обычно указывает на то, что в области шеи начинает формироваться воспаление. Вы чувствуете усталость, можете испытывать потерю аппетита и общий дискомфорт. В случае присутствия этих неприятных проявлений обеспечьте себе спокойствие, расслабление и достаток сна. Во время сна организм естественным образом восстанавливается и набирается сил. Начните также принимать витамин С, который укрепляет защитные силы организма. При простуде также подходит травяной чай. Из локальных обезболивающих продуктов обычно помогают доступные в аптеках препараты, в зависимости от того, какие вы предпочитаете лекарственные формы (спреи, леденцы и пр.).
Болит горло и температура выше 38 °C?
В этом случае состояние своего здоровья не следует недооценивать. Если жар сохраняется и симптомы ухудшаются, обратитесь к врачу. Самолечение может быть эффективным только в начале инфекции. Важно определить, не бактериальная ли это инфекция, при которой необходимо лечение антибиотиками. Причинного лечения (вылечивается причина заболевания) для вирусной инфекции, к сожалению, не существует, терапия может быть только симптоматической (решает проблему последствий инфекции – снимает боль, лихорадку), вводятся лекарства для лечения воспаления. В дополнение к лекарственным препаратам рекомендуется поддерживающий процесс заживления ран, например, полоскания, пастилки для лечения ангины, компрессы, травяные чаи, витамин С.
Рекомендации при болезненности в горле
В основном рекомендации сводятся к следующему:
- Не курите и избегайте задымленных помещений.
- Увлажняйте воздух в помещении, регулярно проветривайте комнату (сухой воздух может вызвать кашель).
- Отдыхайте и обеспечьте себе регулярный и достаточный сон.
- Если у вас есть кондиционер, регулярно кондиционируйте воздух.
- Если температура тела повышается выше 38 °C, обратитесь к врачу.
Как предотвратить боль в горле?
Профилактических мер несколько, они, в основном, зависят от иммунитета организма:
Меры гигиены – регулярное мытье рук (вы можете также использовать дезинфицирующие гели), регулярная гигиена носовой полости (полоскание назальных полостей убивает патогенные микроорганизмы, и нос будет лучше в состоянии выполнить свою защитную функцию), использование индивидуальных столовых приборов (не следует пить из чужой чашки), избегание контакта с больными людьми.
Укрепление иммунитета – регулярные физические упражнения на свежем воздухе, потребление достаточного количества фруктов и овощей, ограничение курения, избегание стресса, достаточное восстановление после заболевания.
Ангина
Ангина (тонзиллит) представляет собой острое воспаление миндалин. В большинстве случаев речь идет о бактериальном заболевании (примерно в 10% случаев – это вирусная или грибковая инфекция). Ангина, как и грипп, распространяется воздушно-капельным путем. Бактерии влияют на лимфоидные ткани в области шеи, особенно миндалины.
Симптомы ангины
Инкубационный период ангины составляет 1–3 дня. С самого начала заболевания симптомы так же, как при гриппе, но затем состояние становится более тяжелым и самолечение не помогает.
Общие симптомы:
- Головная боль.
- Озноб, лихорадка.
- Оталгия.
- Боли в животе, рвота.
Локальные симптомы:
- Покрасневшие и опухшие миндалины, как правило, с белыми гнойными пробками.
- Боль в горле.
- Затруднение глотания, кашель, охриплость.
- Увеличение лимфатических узлов.
- Заложенность носа, насморк.
- Неприятный запах изо рта, слюнотечение.
Профилактика ангины
При лечении ангины следует руководствоваться интенсивностью боли и другими проявлениями инфекции. Боль в горле, как правило, сопровождается симптомами воспаления – покраснение горла, отек, высокая температура.Ангина распространяется особенно весной и осенью, но иногда и летняя жара способна вызвать заболевание, так же, как и резкие колебания температуры. Важно позаботиться о естественной иммунной защите – на здоровое горло бактерии, вирусы и грибы «нападают» реже.
Что делать?
- Ограничьте контакты с больными людьми.
- В течение нескольких «рисковых» месяцев постарайтесь избегать мест с высоким скоплением людей.
- Поддерживайте свою иммунную систему.
- Обеспечьте правильное питание.
- Избегайте питья холодной воды, кондиционера, чрезмерно жарких помещений.
Лечение ангины
Если горло болит дольше, чем 2 дня, и наблюдаются вышеуказанные симптомы респираторной инфекции, обратитесь к врачу, чтобы он назначил соответствующее лечение.
Для лечения ангины почти всегда используются антибиотики (чтобы убить бактерии) и анальгезирующие препараты (для снятия боли). В дополнение к лечению рекомендуется достаточный отдых и полноценный сон, чтобы тело после изнурительных лихорадочных состояний могло легче регенерироваться. Очень важно соблюдение питьевого режима (травяные чаи), снабжение организма витаминами, особенно витамином С. Можно использовать спреи, назальные капли и солевые растворы, помогающие ослабить заложенность носа. Болезненность в горле помогут подавить спреи, жидкости или пастилки.
Ангину в любом случае нельзя игнорировать, даже если у вас наблюдаются только легкие симптомы. В дальнейшем могут появиться более серьезные проблемы, такие как ревматизм, влияющий на сердечные клапаны, суставы и мышцы, или хроническое воспаление почек.
Ангина летом
Ангина может беспокоить не только в осенне-зимний период, но часто и в летнее время. «Летняя» ангина возникает в случае большой разницы между внутренней температурой тела и температурой окружающей среды.
Что вызывает летнюю ангину, и как избежать ее?
Только врач в состоянии определить причину проблемы и назначить подходящие терапевтические методы и лекарственные препараты. Если есть инфекция горла, лечение должно быть своевременным!Кондиционер. Следует помнить, что температура в помещении должна быть не более чем на 5–7 °С ниже, чем внешняя температура. Например, если снаружи +35 °С, а термостат кондиционера в офисе установлен на +20 °С, существует риск иммунодепрессии верхних дыхательных путей. Если вы путешествуете на машине, разница температур должна быть не более 6 °С. Следует помнить, что температура в автомобиле никогда не опускается ниже +21 °С. Если разница между температурой внутри автомобиля и снаружи слишком большая, может произойти даже сосудистый коллапс.
Употребление холодных напитков. Питье слишком холодных напитков приводит к температурному шоку тела, изменяет условия слизистых оболочек горла, глотки и миндалин, что способствует проникновению инфекции. В летнее время поэтому следует пить жидкости комнатной температуры или теплый чай.
Сквозняки. Холодный воздух, которому человек подвергается при сквозняке, ослабляет иммунитет слизистых оболочек в горле. Проблемы также может вызывать вентилятор, который дует воздух в лицо. В таком случае кожа сохнет, возникает жжение глаз.
Заключение
Обнаружив у себя перечисленные выше симптомы, не занимайтесь самолечением, обратитесь к специалисту. Только врач в состоянии определить причину проблемы и назначить подходящие терапевтические методы и лекарственные препараты. При инфекции горла лечение должно быть своевременным!
proinfekcii.ru
Бактериальный тонзиллит: симптомы, как лечить, причины
Бактериальный тонзиллит (ангина) – это инфекционно-воспалительный процесс в миндалинах, возбудителями которого являются бактерии. Чаще всего «виновником» заболевания являются стрептококки, а также стафилококки. Недуг вызывает общие симптомы интоксикации и требует незамедлительного грамотного лечения.
Миндалины являются органами иммунной системы и выполняют защитную функцию в нашем организме. Это своего рода ворота, которые препятствуют проникновению болезнетворных микроорганизмов.
Заболевание вызывает дискомфорт и боли в горле, вплоть до невозможности глотать. Во рту можно обнаружить увеличенные и гиперемированные миндалины, а также гнойный налет на их поверхности. Больной становится вялым, апатичным, у него повышается температура тела и возникают головные боли.
Лечением должен заниматься квалифицированный специалист. Самолечение недопустимо. Нелеченый бактериальный тонзиллит грозит развитием осложнений со стороны сердца, почек и суставов. Прежде чем приступать к лечению, следует сдать анализы для идентификации возбудителя. В противном случае лечебный процесс может не увенчаться успехом.
Основным лечением бактериального тонзиллита является антибиотикотерапия. Исходя из результатов анализов и тяжести патологического процесса, врач подбирает оптимальное антибактериальное средство. Но прежде чем говорить о методах борьбы, рассмотрим этиологические факторы недуга, клиническую симптоматику и патогенез.
Возможные причины
Как уже было сказано, причиной развития патологического процесса в миндалинах является бактериальная инфекция:
- стрептококки;
- стафилококки;
- пневмококки;
- ниссерии;
- кишечная палочка;
- синегнойная палочка;
- хламидии;
- микоплазмы;
- уреаплазмы.
Но не всегда развитие заболевания вызывает патогенная микрофлора, иногда виной тому становятся условно-патогенные микроорганизмы, которые могут обитать в здоровом организме и не вызывать никаких нарушений. Иммунитет человека строго контролирует их численность и не дает этим микроорганизмам активно размножаться. Но под влиянием определенных обстоятельств иммунная система может ослабнуть и в итоге она станет неспособной в полной мере выполнять свою функцию. В итоге условно-патогенная микрофлора выходит из-под контроля, начинает активно развиваться, образовывать целые колонии и в итоге приводить к развитию недуга.

Иммунитет следит за проникновением болезнетворных микроорганизмов
Помимо основной причины, есть предрасполагающие факторы в развитии бактериального тонзиллита:
- снижение местного иммунитета;
- хронические очаги инфекции: синуситы, кариес;
- переохлаждение;
- неправильное питание;
- авитаминоз;
- полипы;
- беременность;
- дефекты носоглотки;
- частые простуды;
- травма миндалин.
Как можно заразиться
Основным способом передачи бактериальной инфекции является больной человек. Наибольшую опасность больной представляет в первые дни болезни. Но с другой стороны человек, который перенес тонзиллит, на протяжении двух-трех недель может выделять бактерии и представлять угрозу для окружающих. Инфекция может проникнуть в организм через использование общей посуды, одежды, а также воздушно-капельным путем.
Виды
В зависимости от частоты проявления недуга, бактериальный тонзиллит бывает двух видов:
- острый. У больного был всего один случай заболевания, который был вызван ослаблением иммунитета или проникновением вредоносной бактерии;
- хронический. Заболевание возникает регулярно, несколько раз в год. Местный иммунитет резко ослаблен, а миндалины попросту не справляются со своей функцией.

Основной путь передачи инфекции – воздушно-капельный
Симптомы бактериального тонзиллита
Для заболевания характерно появление следующих симптомов:
- боли в горле постоянного характера, которые усиливаются во время глотания;
- першение в горле;
- белый налет на миндалинах;
- покраснение и отек миндалин;
- гипертермия;
- головные боли;
- ломота в суставах;
- боли в шее;
- увеличение регионарных лимфатических узлов;
- бессонница;
- слабость, утомляемость, снижение работоспособности.

В отличие от вирусного тонзиллита, для которого характерно появление ринита и конъюнктивита, при бактериальной форме этих симптомов нет, зато течение патологического процесса будет гораздо тяжелее
Вообще, в зависимости от типа возбудителя клиническая картина может отличаться. Так, при стрептококковой форме наблюдается тяжелое течение и высокие риски возникновения осложнений со стороны почек и суставов. Стафилококковая же ангина часто вызывает распространение патологического процесса на близлежащие структуры, а также абсцессы.
Катаральная форма
Это одна из наиболее легких форм бактериального тонзиллита. Начинается недуг внезапно с появления першения и сухости в горле, после чего возникают болевые ощущения.
Больные жалуются на разбитость и головные боли. Обычно температура тела не повышается выше отметки 38. Миндалины отекают, становятся гиперемированными, при этом их поверхность чистая без гнойных скоплений. Обычно катаральная форма длится от трех до пяти дней.
Фолликулярная форма
Обычно процесс начинается с подъема температуры до 38-39 градусов. Человека беспокоит озноб ломота, разбитость, головную боль. Если заболевание возникает у маленьких детей, возможно появление серьезных симптомов: рвота, помутнение сознания, а также признаки менингизма.
Человек не может глотать, это вызывает нестерпимые боли, из-за чего он отказывается от приема пищи. На поверхности миндалин виднеются желтые точки. По величине они напоминают просяное зернышко. После вскрытия гнойных пробок, это происходит примерно на третий день, происходит нормализация температуры и улучшение общего состояния. Обычно фолликулярная форма длится около одной недели.
Лакунарная форма
По своему течению и проявлениям лакунарная ангина протекает по типу фолликулярной, только на порядок тяжелее. В отличие от вышеописанной формы, лакунарный тонзиллит не проявляется в виде гнойный пробок, для этого процесс характерно растекание гноя по всей поверхности миндалин. Налет в этом случае никогда не распространяется за пределами миндалин.
Фибринозная форма
В большинстве своем является осложнением фолликулярной или лакунарной формы. На поверхности миндалин образовываются пленки бело-желтого цвета. Гнойный секрет может покрывать всю поверхность миндалин и даже выходить за их пределы.
Проявления фибринозной формы схожи с дифтерией. Главным отличием является то, что при фибринозном тонзиллите налет снимается легко и попытки его снять не приводят к повреждению миндалин. А вот при дифтерии это сделать трудно и на месте отслоившегося налета появляется кровоточащая поверхность.

В отличие от дифтерии, при фибринозном тонзиллите гнойные пленки легко отходят
Флегмонозная форма
Это довольно редкая форма, и по сути, является интратонзиллярным абсцессом. Это означает, что распространение гноя затрагивает околоминдалиновую клетчатку. Это происходит в результате гнойного расплавления тканей миндалин. Обычно флегмонозный тонзиллит имеет односторонний процесс. Патологический процесс нуждается в оперативном вмешательстве.
Заболевание вызывает такие симптомы:
- миндалина увеличена в размерах, отекшая и напряжена;
- при пальпации миндалина болезненна;
- нарастающая боль в горле;
- затрудненное глотание;
- признаки общей интоксикации.
Возможные осложнения
- Гемолитический стрептококк группы А в случае распространения может привести к поражению соединительной ткани сердца и суставов:
- эндокардит;
- артрит;
- ревматизм;
- гломерулонефрит;
- пиелонефрит;
- миокардит;
- системная красная волчанка;
- склиродермия.

Недолеченный тонзиллит может привести к паратонзиллиту, а также паратонзиллярному абсцессу
Отсутствие должного лечения может привести к переходу острого процесса в хроническую форму. При этом человек начинает жаловаться на постоянное недомогание и распространению бактериальной инфекции по всему организму.
Диагностическое обследование
Обследование начинается со сбора анамнестических жалоб и осмотра пациента. Специалист берет бактериологический посев с зева, который поможет определиться с выбором лекарственного средства.
Также при первичном осмотре врач обращает внимание на состояние глаз и носоглотки. Это поможет в проведении дифференциальной диагностики тонзиллита. Проводится общий анализ крови, из которого можно увидеть наличие воспалительного процесса: увеличение показателей СОЭ, лейкоцитоз. При исследовании лейкоцитарной формулы будет присутствовать повышенное количество палочкоядерных нейтрофилов.

В первые дни заболевания больные с бактериальным тонзиллитом должны соблюдать постельный режим
Как лечить бактериальный тонзиллит
В зависимости от формы заболевание лечение заболевания бывает консервативным и хирургическим. В тяжелых случаях пациента доставляют в инфекционное отделение.
Лечение острой формы
Алгоритм лечебного процесса включает в себя целый комплекс мероприятий:
- соблюдение постельного режима. Если переносить заболевания на ногах, могут возникнуть серьезные осложнения;
- употребление теплого питья в достаточном количестве. Это могут быть травяные чаи, морсы, компоты или простая вода. Жидкость будет ускорять выведение токсических веществ;
- пища должна быть мягкой и не раздражать слизистую оболочку. Следует отказаться от острого и соленого;
- антибиотики назначаются в зависимости от результатов анализа. Даже при улучшении самочувствия долечиться следует до конца, иначе есть риски развития устойчивости бактерий и в следующий раз препарат просто не поможет;
- в качестве обезболивающего средства принимайте препараты на основе парацетамола;
- для укрепления местного иммунитета и борьбы с патогенными микроорганизмами используйте назальные спреи;
- каждые два часа полощите горло антисептическими растворами.
Лечение хронической формы
Вылечить хронический гораздо сложнее, чем острую форму. Борьба с недугом проводится в несколько этапов:
- оздоровление миндалин;
- физиотерапия;
- витаминотерапия.
Медикаментозная терапия
Ввиду того что тонзиллит вызывают бактерии, бороться с ним следует с помощью антибактериальных средств. Только с помощью этой группы лекарственных средств удастся избавиться от микробов и свести на нет инфекционно-воспалительный процесс.
Не стоит себя обнадеживать, что народные средства вылечат недуг, это невозможно, они могут лишь ослабить симптомы тонзиллита, например, боль в горле. Специалисты отдают предпочтение таким антибиотикам:
- Пенициллины. Ампиокс, Амоксициллин;
- Макролиды. Азитромицин, Эритромицин;
- Цефалоспорины. Цефакс, Цефтриаксон.
В зависимости от формы и тяжести недуга антибиотики назначаются в таблетках или инъекциях. Обычно курс антибиотикотерапии длится семь дней. При высокой температуре назначаются жаропонижающие средства. Во избежание развития аллергической реакции в некоторых случаях понадобится применение антигистаминных препаратов.
Местное лечение
Для антисептики миндалин и близлежащих тканей назначаются полоскания горла такими растворами:
- сода;
- фурацилин;
- морская или поваренная соль;
- отвар ромашки;
- экстракт чайного дерева или эвкалипта;
- настойка календулы.
Хирургия
Оперативное вмешательство включает в себя иссечение миндалин. К нему прибегают в том случае, если в течение нескольких лет заболевание часто появляется несмотря на проводимое лечение. Обычно к операции прибегают в случае возникновения абсцесса или других осложнений. Процедура проводится под местным наркозом. В последнее время все большую популярность набирают неклассические методы удаления: лазером или ультразвуком.

Антибиотикотерапия – это основа лечения бактериального тонзиллита
Народная медицина
Уменьшить клинические симптомы острого и хронического тонзиллита могут быть такие рецепты:
- ромашка и липа. Возьмите столовую ложку сырья и залейте кипятком. Средство должно настояться, после чего его процеживают. Использовать средство следует в качестве полосканий горла;
- мед. В стакане теплой воды разведите ложку меда;
- прополис. Маленький кусочек прополиса держите во рту в течение часа. Периодически можно перемещать его из одной части в другую. Прополис – это мощный антисептик;
- пихтовое масло. Нанесите на ватный тампон масло и обработайте им пораженный участок;
- лекарственный сбор. Понадобятся такие компоненты: листья мяты, шалфея, плоды фенхеля и цветки ромашки. Эти растения обладают в комплексе анальгезирующим, антисептическим и заживляющим свойством. Столовую ложку сбора залейте стаканом кипятка и настаивайте в течение сорока минут. Используйте средство в виде полосканий.
Профилактика
Для того чтобы избежать появления бактериального тонзиллита, придерживайтесь следующих рекомендаций:
- следите за состоянием иммунной системы. Для этого ваш рацион должен быть сбалансированным и витаминизированным. Занимайтесь спортом, закаливайте свой организм;
- избегайте контактов с больными людьми и без надобности не бывайте в местах с массовым скоплением людей, которые могут представлять потенциальную опасность;
- избегайте переохлаждений и сквозняков, одевайтесь по погоде;
- регулярно посещайте стоматологический кабинет;
- должным образом проводите гигиену ротовой полости;
- проходите профилактические осмотры;
- откажитесь от вредных привычек, в частности, курения.
Итак, бактериальный тонзиллит – это инфекционное заболевание, которое может вызывать серьезные осложнения. Чтобы этого не произошло, при возникновении тревожных симптомов обращайтесь к врачу. Боль в горле, повышение температуры, отек и покраснение миндалин – все это является симптомами воспалительного процесса. Занимаясь самодиагностикой, вы можете попросту потерять время. Ранняя консультация у врача, точная диагностика и неукоснительное соблюдение врачебным рекомендациям – все это поможет привести ваш организм в норму.
superlor.ru
При лечении ангины следует учитывать интенсивность боли и другими проявления инфекции. Боль в горле, как правило, сопровождается симптомами воспаления – покраснением горла, отеком, высокой температурой.